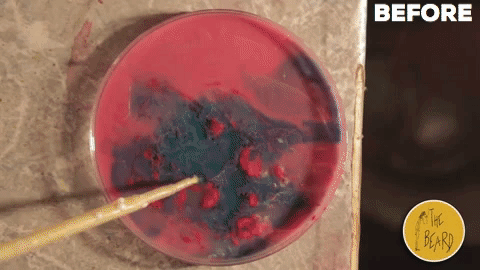

Homemade miniature planets.

It is an inebriating experience to imagine and create alien worlds in the basement of your own home. It is like entering the final laboratory, where the planets are built in test tubes. All it takes is some time and patience (and some milk, alcohol and food coloring).
In my small way, the experiences that gave me more satisfaction, in the creative sphere, are those that mix material techniques with digital effects. The union of the two creates something really satisfying. It's like getting up from the table after eating really well and not feeling weighed down.
The following are the behind the scenes and the final result in the creation of these miniature alien worlds.

Let me know what you guys think.
Until next time.

wow so beautiful!
Thank you! 🙂
Upvoted on behalf of @thehumanbot and it's allies for writing this great original content. Do not use bid bots for at least 1-2 days, as your post may get picked up by top curators.
Great Original Works are rewarded by top Curators.If you like this initiative, you can follow me in SteemAuto and upvote the posts, that I upvote.
And remember to do some charity when you are rich by contributing to me.If you have any concerns or feedback with my way of operation, raise it with @sanmi , my operator who is freaking in Steemit chat or discord most of the time.
Thank you! I don’t plan on using bid bots anytime soon. I just want to share my content. If people like it that’s great, if not I’m cool 😁
Very cool!
Thank you Old Dog! : )
Great work of art my friend! you have such a creative mind!
By the way, you have been scouted by @promo-mentors. We are always on the look-out for promising authors.
I would like to invite you to our discord group where we are a community that fosters camaraderie and help authors improve their blogging skills where we have mentors that conduct post feedback sessions and other things.
If you have time, do check us out!
https://discord.gg/vDPAFqb.
When you are there send me a message if you get lost! (My Discord name is the same as the one here)
Thank you @andywong31!
I will definitely join your discord channel.
It’s all so new. I wouldn’t mind a mentor : )
Oh fantastico! L'ultimo sembra il nostro pianeta con un qualche problemino a nord dell'Australia, haha.
Ahahahah! Grazie.
C’avevo pensato anch’io all’Australia. Però è stato un puro caso. Stavo cercando di riprodurre l’Europa e mi è uscita l’Oceania 😂 si può sempre migliorare.
A presto!
Very cool art project!
Thanks to @randomwanderings, this post was resteemed and highlighted in today's edition of The Daily Sneak.
Thank you for your efforts to create quality content!
Thank you for your support! It’ greatly appreciated 😊